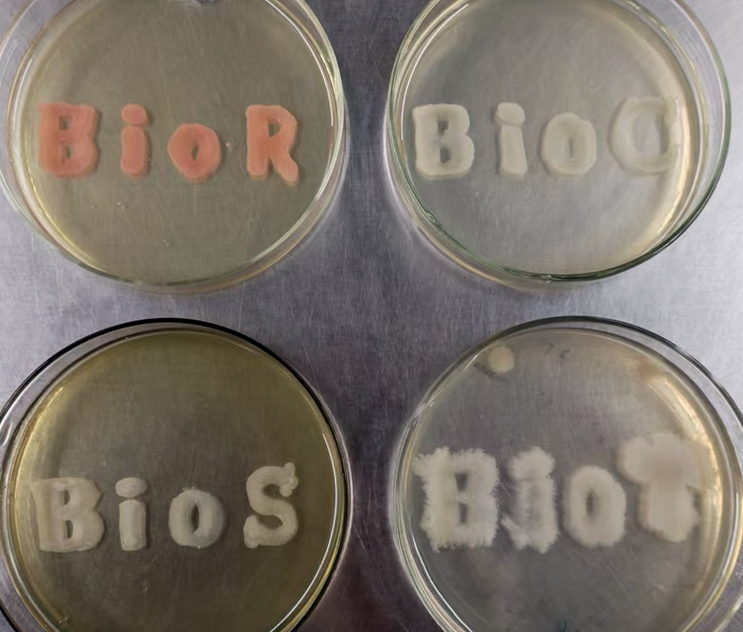

个 人 简 历
| 舒正玉,博士,教授,博士生导师 |
生命科学学院食品科学与工程系 工业微生物国家地方联合工程研究中心 | |
E-mail: shuzhengyu@fjnu.edu.cn |
教育经历
2004.9-2007.7 华中科技大学生命科学学院,理学博士学位(生物化学与分子生物学专业)。
2000.9-2003.7,华中农业大学生命科学学院,理学硕士(微生物学专业);
1991.0-1995.7,湖北大学生命科学学院,理学学士(生物教育)。
工作经历
2012.8-2013.8,瑞典皇家理工学院生物技术学院访学(国家留学基金委资助);
2007.8——,福建师范大学生命科学学院讲师/副教授/教授/博士生(硕士生)导师;
1995.8—2000.8,华中农业大学附属中学。
研究方向和领域
本课题组的研究领域为工业酶制剂开发与分子修饰,主要围绕下列三个研究方向开展研究工作:
(1) 菌种资源库与基因资源库的建立。本研究方向基于课题组自主建立的定向筛选技术,持续多年筛选特定微生物菌群(工业应用和食品加工领域)、挖掘并克隆了一系列重要工业生物催化剂基因资源(主要为EC1、EC2和EC3类)。同时利用特色菌株,合成或转化小分子化合物(药物前体分子)。选修本研究方向的学生将掌握微生物技术(含生理生化)、基因工程技术、生物信息学技术等技能(参考阅读论文8, 13和19等)。
|
(2) 工业生物催化剂的开发与制备。基于工业生物催化剂制备与应用过程中存在的稳定性与重复利用等问题,开发各种表达体系,实现酶蛋白编码基因的异源高效表达;利用蛋白质工程技术,改造并提升酶学性质;开发各种固定化材料,制备高效催化的酶制剂。选修本研究方向的学生将掌握基因工程技术、蛋白质工程技术、酶学性质分析技术、高分子材料的合成与修饰、分子动力学模拟等技能(参考阅读论文1,7,11和3等)。
|
|
|
(3) 生物大分子和天然化合物的酶法修饰。利用课题组自主开发的各种酶制剂,对生物大分子(蛋白质和多糖)和小分子化合物进行修饰,改善其理化性质(稳定性、溶解性、肠道吸收效率及其他生理活性、毒物脱毒等)。选修本研究方向的学生将掌握生物化学技术、酶学性质分析技术、各类色谱技术、分子动力学模拟等技能(参考阅读论文:1,5,9和12等)。
|
|
科研项目
(1) 国家自然科学基金面上项目(2019.01-2022.12),主持;
(2) 国家自然科学基金面上项目(2014.01-2017.12),主持;
(3) 国家自然科学基金面上项目(2009.01-2011.12),主持;
(4)福建省自然科学基金面上项目(2021.11-2024.11),主持;
(5) 福建省自然科学基金面上项目(2017.1-2020.4),主持;
(6) 福建省科技厅重点项目(2013.3-2016.2),参与/第二完成人;
(7) 福建省自然科学基基金杰青项目(2009.3-2012.12),主持;
科技论文
(1) Jiamin Gao, Wenxin Gao, Wenjing Jia, Yuling Wang, Feng Li, Xiangduo Mu, Shiqi Yu, Xiaoxia Li, Jianzhong Huang, Zhengyu Shu*. Enzymatic synthesis of phytosterol esters using recombinant E. coli whole cell expressing lipase from Burkholderia sp.LWT-Food Science and Technology, 2025, 229:118213
(2) Yanqi Liu, Lydia Mathew, Chaofan Yu, Liang Fu, Zhengyu Shu*, Shobhna Kapoor*, Mojie Duan*. The molecular mechanism of fluorescence lifetime of fluorescent probes in cell membranes. The Journal of Physical Chemistry Letters, 2024, 15(50): 12293-12300.
(3) Kuan Liang, Wanqian Dong, Jiamin Gao, Rui Zhou, Jiawen Chen, Zhengyu Shu*, Mojie Duan*. The conformational transitions and dynamics of Burkholderia cepacia lipase regulated by water-oil interfaces. Journal of Chemical Information and Modeling, 2023, 63: 3854-3864.
(4) Wanqian Dong, Rui Zhou, Jiawen Chen, Zhengyu Shu*, Mojie Duan*. Phosphorylation regulation on the homo-dimeric binding of transactive response DNA-binding protein. Journal of Chemical Information and Modeling, 2022, 62: 5267-5265.
(5) Huan Li, Feng Qin, Lijuan Huang, Wenjing Jia, Mingliang Zhang, Xin Li, Zhengyu Shu*. Enzymatic synthesis of 2-phenethyl acetate in water catalyzed by acyltransferase from Mycobacterium smegmatis (MsAcT). RSC Advances, 2022, 12:2310-2318.
(6) Wenjin Jia, Huan Li, Qian Wang, Hong Lin, Xin Li, Jianzhong Huang*, Linting Xu, Wanqian Dong, Zhengyu Shu*. Screening of perhydrolases to optimize glucose oxidase-perhydrolase-in situ chemical oxidation cascade reaction system and its application in melanin decolorization. Journal of Biotechnology, 2021, 328: 106-114.
(7) Hong Jiang, Wenjing Jia, Mojie Duan*, Hong Lin, Jianzhong Huang*, Xin Li, Zhengyu Shu*. Enhancement of hydrogen peroxide tolerance of lipase LipA from Bacillus subtilis using semi-rational design. Biochemical Engineering Journal, 2020, 159: 107590
(8)王倩,李欢,郑琳,贾文敬,黄建忠*,李欣,董思圳,舒正玉*. 植物根际芽胞杆菌菌种资源采集及其具有过水解催化活性水解酶基因的克隆. 微生物学通报,2020, 47(1):76-87.
(9) Hong Lin, Xiangduo Mu, Jianzhong Huang*, Hong Jiang, Jinghong Niu, Zhengyu Shu*. Comparative analysis of polyester‐hydrolysis activity among three lipolytic enzymes. Journal of Chemical Technology and Biotechnology, 2019, 94(8):2522-2528.
(10)刘艳如*, 李鑫, 董盼盼, 黄建忠, 舒正玉*. 基于空腔填充效应构建伯克霍尔德菌脂肪酶LipA的热稳定性突变体. 微生物学报,2019,59(8):1535-1546.
(11)刘艳如*, 赵丙春, 董盼盼, 邱黎清, 黄建忠, 朱晓兰, 王作镇, 舒正玉*. 理性设计盐桥构建伯克霍尔德菌脂肪酶热稳定突变体. 微生物学报,2017,57(7):1014-1025.
(12) Zhengyu Shu*, Hailong Wu, Hong Lin, Ting Li, Yanru Liu, Fei Ye, Xiangduo Mu, Xin Li, Xianzhang Jiang, Jianzhong Huang. Decolorization of Remazol Brilliant Blue R using a novel perhydrolase-ISCO (in situ chemical oxidation) coupled system. Biochemical Engineering Journal, 2016, 115: 56-63.
(13) Zhengyu Shu*, Hong Lin, Shaolei Shi, Xiangduo Mu, Yanru Liu, Jianzhong Huang*. Cell-bound lipases from Burkholderia sp. ZYB002: gene sequence analysis, expression, enzymatic characterization, and 3D structural model. BMC Biotechnology, 2016, 16:38
(14)刘艳如*,邱黎清,黄建忠,赵丙春,王作镇,朱晓兰,高媛媛,舒正玉*. 热稳定性伯克霍尔德菌脂肪酶A突变体的筛选. 微生物学报,2015, 55(6): 748-754.
(15) Zhengyu Shu*, Jiguang Wu, De Chen, Lanxing Cheng, Yi Zheng, Jianping Chen, Jianzhong Huang*. Optimization of Burkholderia sp. ZYB002 lipase production for pitch control in thermomechanical pulping (TMP) processes. Holzforschung, 2012, 66(3):341-348.
(16) Zhengyu Shu*, Jiguang Wu, Lanxing Cheng, De Chen, Yongmei Jiang, Xin Li, Jian-Zhong Huang*. Production and characteristics of the whole-cell lipase from organic solvent tolerant Burkholderia sp. ZYB002. Applied Biochemistry and Biotechnology, 2012, 166 (3): 536-548.
(17) Zhengyu Shu*, Jiguang Wu, Longyin Xue, Ruifeng Lin, Yongmei Jiang, Lianghua Tang, Xin Li, Jianzhong Huang*. Construction of Aspergillus niger lipase mutants with oil-water interface independence. Enzyme and Microbial Technology, 2011, 48 (2): 129-133.
(18) Zhengyu Shu, Huan Jiang, Ruifeng Lin, Yongmei Jiang, Lin Lin, Jianzhong Huang*. Technical methods to improve yield, activity and stability in the development of microbial lipases. Journal of Molecular Catalysis B: Enzymatic, 2010, 62 (1): 1-8.
(19) Zhengyu Shu, Ruifeng Lin, Huan Jiang, Yanfeng Zhang, Mingzi Wang, Jianzhong Huang*. A rapid and efficient method for directed screening of lipase-producing Burkholderia cepacia complex strains with organic solvent tolerance from rhizosphere. Journal of Bioscience and Bioengineering, 2009, 107(6): 658-661.
(20) Zhengyu Shu*, Mojie Duan, Jiangke Yang, Li Xu, Yunjun Yan*. Aspergillus niger lipase: heterologous expression in Pichia pastoris, molecular modeling prediction and the importance of the hinge domains at both sides of the lid domain to interfacial activation. Biotechnology Progress, 2009, 25(2): 409-416.
(21) Shu ZhengYu, Yang Jiang-Ke, Yan Yun-Jun*. Purification and characterization of a lipasefrom Aspergillus niger F044. Chinese Journal of Biotechnology, 2007, 23 (1): 96-100.
(22) Zheng-Yu Shu, Yun-Jun Yan*, Jiang-Ke Yang, Li Xu. Aspergillus niger lipase: gene cloning, over-expression in Escherichia coli and in vitro refolding. Biotechnology Letters, 2007, 29: 1875-1879.
授权发明专利
已授权发明专利6项(202211116546.4, 202310761791.9, 201810897088.X, 201810898640.7, 201810897089.4和201811278839.6,均为工业酶制剂开发与制备方向),欢迎对工业酶制剂开发有技术需求企业联系与合作。
招生名额及要求
每年招收生物学专业硕士研究生2-3名;生物与医药(专硕)硕士生 1名;微生物学博士生1名。身心健康,严谨刻苦,热爱科研,能熟练阅读英文文献
联系方式
地址:福建省福州市福建师范大学旗山校区生命科学学院理工楼13-506室
邮编:350117
Email:shuzhengyu@fjnu.edu.cn
QQ:26563672